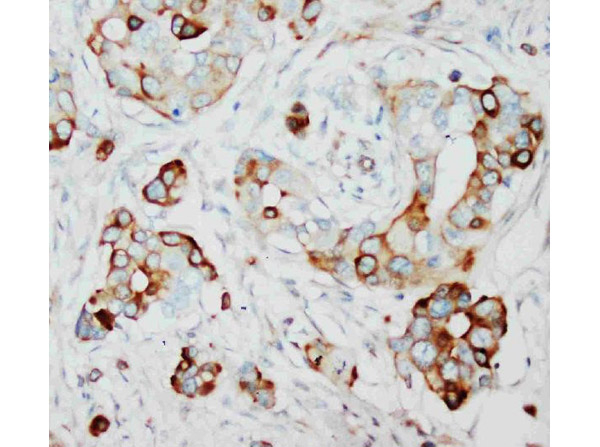
SKP2 Antibody in Immunohistochemistry (Paraffin) (IHC (P))

Search
Rockland
SKP2 Polyclonal Antibody
{{$productOrderCtrl.translations['antibody.pdp.commerceCard.promotion.promotions']}}
{{$productOrderCtrl.translations['antibody.pdp.commerceCard.promotion.viewpromo']}}
{{$productOrderCtrl.translations['antibody.pdp.commerceCard.promotion.promocode']}}: {{promo.promoCode}} {{promo.promoTitle}} {{promo.promoDescription}}. {{$productOrderCtrl.translations['antibody.pdp.commerceCard.promotion.learnmore']}}
产品信息
600-401-P70
种属反应
宿主/亚型
分类
类型
抗原
偶联物
形式
浓度
规格
纯化类型
保存液
内含物
保存条件
运输条件
靶标信息
Skp2 (S-phase Kinase-associated Protein 2) belongs to the family of F-box proteins that interact with the Cyclin A-Cdk2 complex. Skp2 is essential for the G1-S transition in both transformed cells and diploid fibroblasts. Biochemical and genetic experiments have demonstrated that Skp2 is required for the ubiquitination and consequent degradation of p27 in cultured mammalian cells and in vitro reconstitution assays. In normal tissues, Skp2 is expressed in tonsil and placenta. In tumor tissues, Skp2 is expressed widely, in some colon, prostate, pancreas, and skin cancers, with high expression in lung, breast, ovarian, and endometrial cancers. Research suggests that Skp2 plays a role in oncogenesis, particularly in the pathogenesis of lymphomas and breast cancers.
⚠WARNING: This product can expose you to chemicals including mercury, which is known to the State of California to cause birth defects or other reproductive harm. For more information go to www.P65Warnings.ca.gov.
仅用于科研。不用于诊断过程。未经明确授权不得转售。
篇参考文献 (0)
生物信息学
蛋白别名: CDK2/cyclin A-associated protein p45; cyclin A/CDK2-associated protein p45; Cyclin-A/CDK2-associated protein p45; F-box protein Skp2; F-box/LRR-repeat protein 1; F-box/WD-40 protein 1; FWD1; MGC1366; OTTHUMP00000221389; p45skp2; S-phase kinase-associated protein 2; S-phase kinase-associated protein 2 (p45); S-phase kinase-associated protein 2, E3 ubiquitin protein ligase; unnamed protein product
基因别名: 4930500A04Rik; FBL1; FBXL1; FLB1; FWD1; p45; RGD1562456; SKP2
UniProt ID: (Human) Q13309, (Mouse) Q9Z0Z3
Entrez Gene ID: (Human) 6502, (Rat) 294790, (Mouse) 27401